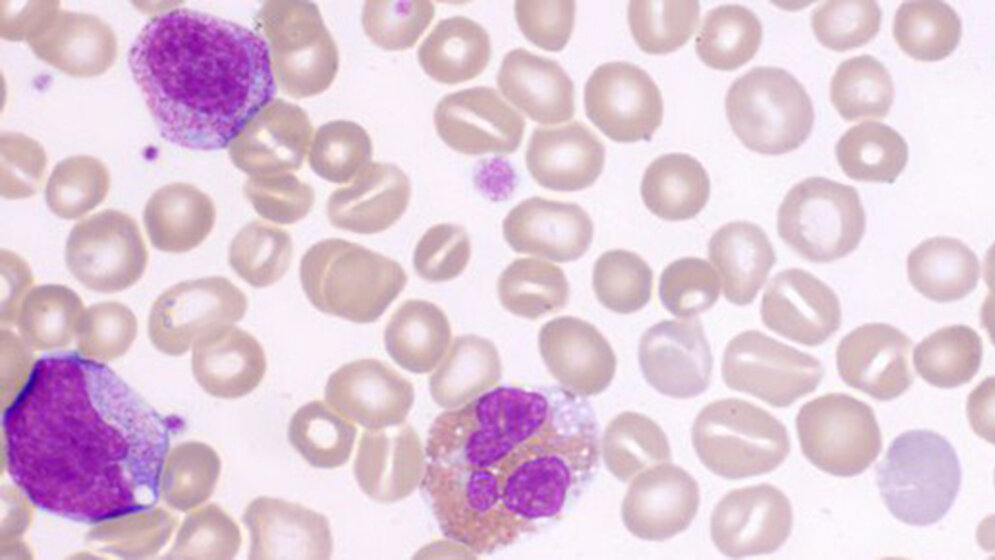
Stomatozyt – Der überwässerte Erythrozyt

Stomatozyten (griech. stoma = Mund) stellen eine Formvariante der Erythrozyten dar, die im lichtmikroskopischen Bild eine mund- oder schlitzförmige zentrale Aufhellungszone aufweist. Elektronenmikroskopisch erscheinen Stomatozyten wie eine Schüssel oder taschenförmig. Die Ursachen für eine Stomatozytenbildung sind vielfältig. Blutgesunde können einen geringen Teil Stomatozyten im Blutausstrich aufweisen (<3%, d.h. < 6 pro Gesichtsfeld, Objektiv 100).
Entnommen aus MTA Dialog 10/2015
Dann nutzen Sie jetzt unser Probe-Abonnement mit 3 Ausgaben zum Kennenlernpreis von € 19,90.
Jetzt Abonnent werden